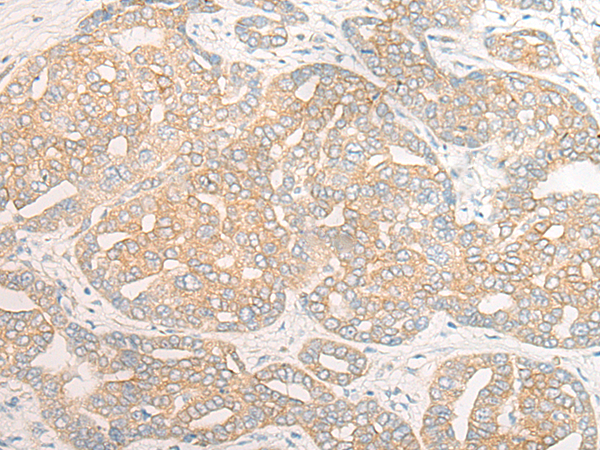

-
分类: 科研抗体货号: P13249别名: G6PT1; G6PT2; G6PT3; GSD1b; GSD1c; GSD1d; TRG19; TRG-19; PRO0685应用: WB,IHC反应种属: Human, Mouse
-
分类: 科研抗体货号: P13250别名: AEZ; ZIP4; AWMS2应用: IHC反应种属: Human
-
分类: 科研抗体货号: P13248别名: CNT2; HCNT2; SPNT1; HsT17153应用: IHC反应种属: Human, Mouse, Rat
-
分类: 科研抗体货号: P13270别名: DAP4; DLP4; DAP-4; SAPAP4; SAPAP-4应用: IHC反应种属: Human, Mouse, Rat
-
分类: 科研抗体货号: P13282别名: ACG; ZIZ2; bB128O4.1应用: IHC反应种属: Human, Mouse
-
分类: 科研抗体货号: P13269别名: F56; DLC1; DLC-1; CFAP81应用: IHC反应种属: Human
-
分类: 科研抗体货号: P13281别名: ZIZ1; ZIZIMIN1应用: IHC反应种属: Human
-
分类: 科研抗体货号: P13268别名: SPF31; HSPC331应用: IHC反应种属: Human, Mouse, Rat
-
分类: 科研抗体货号: P13280别名: DOC2BL应用: IHC反应种属: Human, Mouse, Rat
-
分类: 科研抗体货号: P13267别名: CCD1应用: IHC反应种属: Human, Rat

鄂公网安备42018502007531号
鄂公网安备42018502007531号

